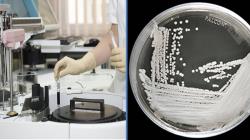

90天奪命!這5種族群當心神秘超級病菌威脅
麥寮六輕氣爆停工 台化:月營收短少10億

▲雲林縣麥寮六輕工業區台化芳香烴三廠7日下午發生氣爆案。(圖/中央社)
台塑集團位於雲林麥寮六輕園區的台化(1326-TW)芳香烴三廠,7日下午因液體石油儲槽 LPG 管線洩漏事故導致氣爆,遭雲林縣府依空氣污染防制法開罰新台幣500萬元,目前事故發生廠房已全面停工進行安檢。台化表示,此次爆炸事故估計影響二甲苯外售量約3萬噸,月影響營業額約10億元,但對營運沒有重大影響。

▲台化副董事長洪福源。(圖/anue鉅亨網)
關於此次爆炸事故,台化今日開盤前發出重訊,指ARO-3廠(芳香烴3廠)因製程LPG管線洩漏引發閃然,製程緊急安全停車,人員無傷亡,火勢已控制,對營運沒有重大影響。
台化表示,ARO-3廠主要產品為苯及對二甲苯,苯供自用,且苯乙烯廠及苯酚廠安排定檢中,對營收並無影響。對二甲苯除自用外尚有外售,估計影響外售量約3萬噸,月影響營業額約10億元。
而台化今日股價表現在台塑四寶中相對弱勢,台塑(1301)開盤報108元,南亞(1303)開盤報78.3元,兩檔個股早盤狹幅震盪,沿平盤線游走;台化(1326)開盤報108.5元,早盤跌0.46%;台塑化(6505)開盤報115元,早盤跌0.44%。


▲(圖/翻攝自Yahoo奇摩股市)

雲林縣麥寮六輕工業區台化芳香烴三廠7日發生氣爆,周邊鄉鎮市民眾幾乎都能聽到巨響,幸未傳出人員傷亡。縣府將依空污法重罰新台幣500萬元,且於調查報告出爐前,勒令停工。
雲林縣消防局於7日下午2時5分左右接獲報案,麥寮六輕工業區台化芳香烴三廠發生氣爆,立即調派麥寮等多個分隊、各式救災救護車輛前往搶救,研判是LPG管線去乙丁烷塔破裂引起,救災人員均穿著防護裝備,火勢於下午4時6分控制,所幸未傳出人員傷亡。

▲雲林縣麥寮六輕工業區台化芳香烴三廠7日下午發生氣爆案。(圖/中央社)
雲林六輕台化芳香烴三廠發生氣爆,由於氣爆威力強大,周邊鄉鎮市民眾幾乎都能感受到巨大聲響,就連雲林縣山區的林內鄉的民眾也有聽到巨響,還有民眾誤以為是中國打過來了,鄉親們議論紛紛。
台塑六輕麥寮管理部副總經理陳文仰表示,事故發生時,立即啟動廠區消防搶救作為,並通報消防局,幸未傳出人員傷亡;台化芳香烴三廠將暫時停止運作,全面檢修管線,另外,後續會調查影響的範圍,並補償受波及的居民。
氣爆事故發生後,雲林縣長張麗善第一時間趕抵六輕關心與了解災情,並對災害發生後續處理做出指示,包括成立事故調查小組,3天內提出發生的原因與真相。要求六輕進行管線總體檢,提出具體管線汰換等相關工程。
另外,縣府將依空污法第32條重罰500萬元。鄰近漁塭、民宅如有損害,由六輕負責修復。事故發生範圍內,於調查報告出爐前,勒令停工。鑑於六輕為亞洲最大石化廠區,當負起企業責任,研議成立國際級的災害應變小組,嚴謹做好相關工安工作。

▲雲林縣麥寮六輕工業區台化芳香烴三廠7日發生氣爆,大量濃煙直竄天際。(圖/中央社)
根據「六輕公安網」及雲林縣政府新聞網站資料,六輕工業區歷年工安意外,自2010年7月間起,台塑公司麥寮輕油裂解廠煉製二廠重油外洩火災,直到2019年4月間,台化公司芳香烴3廠,LPG管線去丁烷塔破裂,這段期間已發生十餘起工安意外。

雲林縣麥寮鄉六輕工業區台化芳香烴三廠下午2時10分驚傳發生爆炸案,火光濃煙數公里外可見,雲林縣消防局目前趕往現場救災。而對此,廠方初判是台化廠出狀況,並且初步瞭解是200區LPG(液化石油氣)管破裂,至於確實原因仍待釐清。

▲六輕煉油廠爆炸的轟天巨響把附近民眾都嚇壞。(圖/東森新聞畫面)
而六輕煉油廠爆炸的轟天巨響也把附近民眾都嚇壞,不僅現場烈焰沖天,濃煙更是不斷竄出,不少民眾紛紛拍下爆炸現場瘋傳。而稍早台塑集團總管理處也表示,初步確定沒有人員傷亡,詳細狀況,台化稍晚會發布訊息說明。

▲稍早台塑集團總管理處表示,初步確定沒有人員傷亡。(圖/東森新聞畫面)
此外,不少附近居民表示,下午聽見好大一聲巨響,接著就看見六輕傳出濃煙,並紛紛在地方社團留言,「希望工作人員平安無事」、「先關窗」、「超大聲」、「好恐怖」、「好可怕!!!連麥寮鄉內整個房子都在動…玻璃都破了!!!」。

麥寮汽電公司因雲林縣政府緊縮生煤許可,無法配合台電調度發電;因此,台電要求給付替代成本32.8億元。麥寮汽電總經理曹明表示,雙方協商多次不成,只好走上法律途徑。

▲近日麥寮汽電收到台電來函表示,要求要支付前年未發滿的不足電度的替代成本約32.8億元。( 圖 / 取自 麥寮汽電 官網 )
麥寮汽電14日指出,雲林縣政府限縮發電機組操作許可證生煤量,導致2017年底許可量用罄後被迫停機無法配合台電調度。台電來函稱其不足電度的替代成本為新台幣32億8450萬8748元,並要麥電在今天(15日)前給付。

▲麥寮電廠公告指出,去年底許可量用罄後,被迫停機無法配合台電調度。( 圖 / 取自 麥寮汽電 官網 )
曹明表示,麥電主張生煤減量為政府公權力行為,屬合約不可抗力範圍,若台電逕行扣款,麥電將依法採取適當的保全程序。
曹明指出,台電還未支付2018年的麥電發電費用,加上麥電和台電公司協商多次未果,中間也請政府單位出面協助解決,但台電仍堅持要求麥電支付替代成本;因此必須要走上法律途徑,否則台電年年都會要求麥電支付替代成本,麥電既不能違反縣府的命令,又礙於與台電的合約限制,麥電無法找出雙贏的解決方案。

▲麥寮電廠共有3部燃煤機組,合計總容量180萬瓩。( 圖 / 取自 麥寮汽電 官網 )
台電發言人徐造華表示,雙方對於合約有不同見解;不過根據合約第48條規定,「各種許可或證照無法取得或更新,非屬不可抗力」,已在合約中載明。台電會依照合約減少支付電費,會先從上個月的電費抵扣,不足額會再從下個月電費扣,直到金額達到32億8450萬元。
對於麥寮電廠將依法採取適當保全程序,徐造華表示,台電予以尊重,希望一切依照合約進行處理。

▲台電發言人徐造華表示,雙方對於合約有不同見解;不過根據合約第48條規定,「各種許可或證照無法取得或更新,非屬不可抗力」,已在合約中載明。( 圖 / 取自 台灣電力工會 )
經濟部能源局多次居中協調,台電及麥電也曾找「電業爭議調處審議會」調解,但都未能解決。
根據台電官網,麥寮電廠共有3部機組、裝置容量合計共180萬瓩。

近來國人關切空氣汙染議題,作為基載電力的燃煤電廠屢屢成為箭靶,台塑企業示警,地方政府競相減煤或禁燒生煤,將會造成全國燃煤電廠運轉崩盤。
去年12月公布欲修正的《空汙法》草案,導致地方政府核發展延操作許可證標準不一,逕相加碼削減排放量,成為企業不確定的投資障礙,這次修法統一展延許可審查原則,核發展延許可證效期至少給3年,展延未准駁前,企業可不停爐,訂定所謂「台塑」、「台化」條款。
此外,同時增訂「台化條款」,只要許可證屆滿前,地方政府未完成准駁,企業仍可依原本許可證內容繼續操作,不必停工;且要求地方主管機關,除非有特殊情形,不得隨意變更許可證內容。如此可避免企業因停工巨大損失,解決企業因許可證變更而增加設備調整成本。

▲(圖/翻攝自東森新聞)
然而,台塑企業表示,能源管理應由中央統籌,不應下放地方有裁量權,倘各縣市政府競相限縮或禁燒生煤,將會造成全國燃煤電廠運轉崩盤,恐發生限電危機及電價飛漲,衍生對經濟、民生長期發展的重大損害。
因雲林縣府對麥寮汽電下達減煤令,以致麥電2部燃煤機組去年停止運轉2個月,致麥電少發約8億度電,營收因此減少逾14億元,同時又面臨台電以未依約供電的求償,麥電成了冤大頭。
台塑企業進一步指出,事實上燃煤機組「超低排放」技術已漸成熟,空汙排放已趨近燃氣機組,建議中央應提高應採用效率佳、汙染排放低的燃煤機組的發電占比,只要嚴格管制管末排放量,就可符合環保與經濟效益。
台塑企業表示,目前麥寮電廠實際排放都達到雲林縣府加嚴標準,未來擬繼續投資30億元於汙染防制設備,期達到與台電林口電廠超超臨界發電機組的排放標準。
【往下看更多】
►算力之後換電力? 「這家」20年MOSFET老兵 靠800V悄悄超車
►台股衝上4萬7! 三大法人買超708億 「這檔ETF」外資買最多
►Google攜手聯發科出大招! 郭明錤曝「這隻魚」 讓發哥營收飛天
【熱門排行榜】
►記憶體大漲原因找到了! 科技廠降級避難 DDR2意外上演大復活
►Google攜手聯發科出大招! 郭明錤曝「這隻魚」 讓發哥營收飛天
►大樂透衝3.6億! 4生肖必須買 財神爺在「這方位」